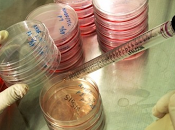
Stamina, annulla Comitato scientifico parere. Tutto rifare. testo della sentenza

Programmi TV — Il Fatto
Programmi TV — Il Fatto
-
“sunshine” sonny payne
Il blues, la radio e una voce leggendaria Il 21 novembre del 1941, da radio KFFA, che trasmetteva dal cuore del Delta a Helena in Arkansas a due passi dal... Leggere il seguito
Il 06 dicembre 2013 da Bluesmusic
NONE -
Rick holmstrom
Una sei corde al servizio del blues Nato a Fairbanks nel cuore dell’Alaska il 30 maggio del 1965, Rick Holmstrom è oggi uno dei chitarristi più stimati e... Leggere il seguito
Il 06 dicembre 2013 da Bluesmusic
NONE -
Rebekah Brooks, 6 mila euro per foto del Principe William in bikini

LONDRA – Rebekah Brooks pagò un funzionario pubblico 4 mila sterline nel 2006 per una foto del Principe William in bikini a un party a cui prese parte anche... Leggere il seguito
Il 06 dicembre 2013 da Ladyblitz
NONE -
Storia di una vita fragile e (pre)potente: ricordando nelson mandela

Sul valore che regole ed esempi possono attribuire alla vita umana si è detto, scritto, pensato e parlato moltissimo: "Con la parola alla gente non si fa nulla. Leggere il seguito
Il 06 dicembre 2013 da Alessandro
NONE -
Un fiume d’Arte – esposizione di opere di Giuliano Ziveri a Birschel Mill...

Il 9 Novembre 2013 è stata inaugurata dall’Assessore della Cultura di Hattinger, Beate Schiffer, e dal Console Dr. Alfredo Casciello una mostra di opere di... Leggere il seguito
Il 06 dicembre 2013 da Giulianoziveri
NONE, NONE -
D’Annunzio: divo o superuomo?

Il vate D’Annunzio, abile imprenditore del suo successo, affascina tuttora per la sua capacità di oltrepassare se stesso, sia nell’arte che nella vita A 150 ann... Leggere il seguito
Il 06 dicembre 2013 da Rodolfo Monacelli
-
La genesi di Superman – Parte seconda (iconografia)
Prosegue il viaggio alla scoperta di predecessori e fonti illustri di Superman. È la volta dell'iconografia: quanti e quali eroi, mascherati e no, ci sono... Leggere il seguito
Il 06 dicembre 2013 da Lospaziobianco.it
NONE, NONE, NONE -
Tre gemelle uguali nascono in California (foto): l’evento è rarissimo

LOS ANGELES – Abby, Brindabella (o Brin) e Laurel sono nate il 22 novembre al Sutter Memorial Hospital di Sacramento in California. Leggere il seguito
Il 06 dicembre 2013 da Ladyblitz
NONE, NONE -
Per la realizzazione di una canna fumaria, quali sono le norme da rispettare?

L’esecuzione di piccole opere sia interne che esterne sono generalmente sottratte al rispetto di specifiche norme di settore, ma è sempre così anche nel caso... Leggere il seguito
Il 06 dicembre 2013 da Ediltecnicoit
NONE -
Presentazione 15° giornata di Serie A
Accenno di fuga della Juventus, frena ancora la Roma, ripartono Napoli e Fiorentina, perde un’altra occasione l’Inter e si rialza il Milan. Leggere il seguito
Il 06 dicembre 2013 da Simo785
NONE -
La biodiversità, lo scambio dei semi, l’identità del territorio.

Intervista di Luigi Trotta a Flavio Polo, agricoltore di Presicce, in provincia di Lecce, proprietario dell’azienda agricola “Campolisio”.http://www.campolisio. Leggere il seguito
Il 06 dicembre 2013 da Antoniobruno5
NONE, NONE -
Gaia, due settimane al lancio

Il logo della campagna di lancio di GAIA (Crediti: ESA)di Marco CastellaniE’ così che dopo anni di preparativi, possiamo finalmente esclamare “ci siamo quasi!”. Leggere il seguito
Il 06 dicembre 2013 da Sabrinamasiero
NONE, NONE, NONE -
Una renna...

Con un forte male alla testa, brividi di freddo, un pò di nausea ma con il piacere di un tea bollente ed il camino acceso ho pensato di farvi vedere una delle... Leggere il seguito
Il 06 dicembre 2013 da Cuoreantico
NONE, NONE, NONE -
fronte/verso di dicembre 2013: perchè conoscere è comprendere
conoscere il diritto è un dirittofronte versoPerché Fronte/Verso? Il linguaggio specialistico è un codice a volte complicato da decifrare per i non addetti ai... Leggere il seguito
Il 06 dicembre 2013 da Albamontori
NONE, NONE -
Ancora Nibiru, ancora un’altra smentita

Penso che, complice anche il 21 dicembre 2012, l’argomento principe che ci ha fornito piu’ spunti per ragionare e parlare di scienza sia stato senza ombra di... Leggere il seguito
Il 05 dicembre 2013 da Psicosi2012
NONE, NONE -
Art tipaldi
Storia di una passione Art Tipaldi ha insegnato letteratura e scrittura creativa ai ragazzi di un liceo di Boston per trentacinque anni. In tutti quegli anni Ar... Leggere il seguito
Il 05 dicembre 2013 da Bluesmusic
NONE -
Anteprima "Ti aspettavo" di J.Lynn alias di Jennifer L. Armentrout. Arriva...

Ho letto questo libro a Maggio, in lingua originale e me ne sono innamorata. L'ho recensito per voi (qui) e vi ho contagiata con il mio amore, tanto da farvi... Leggere il seguito
Il 05 dicembre 2013 da Glinda
NONE, NONE -
Rai, ecco il piano fiction 2014 da 182 mln di euro all'esame del prossimo Cda...

Il piano fiction 2014 sarà sul tavolo del Cda Rai il prossimo 12 dicembre per un approfondimento, dopo l'illustrazione della scorsa settimana ai consiglieri. Leggere il seguito
Il 05 dicembre 2013 da Nicoladki
NONE, NONE -
Vipcancro

Intervista collettiva ai VipCancro, quartetto di base a Marina di Pietrasanta, che già in passato aveva dimostrato di possedere quel talento tutto italiano per... Leggere il seguito
Il 05 dicembre 2013 da The New Noise
NONE -
Un diciannovenne di Nottingham spende 450 sterline per una foto di Xbox One -...
Una console sottilissima A lancio di ogni nuova console ci potrebbe essere spazio per una rubrica fissa su casi di questo genere: un ragazzo di Bilborough ha... Leggere il seguito
Il 05 dicembre 2013 da Intrattenimento
NONE, NONE -
Rai, nuovo piano fiction da 182mln di euro all'esame del prossimo cda

Il piano fiction 2014 sara' sul tavolo del Cda Rai il prossimo 12 dicembre per un approfondimento, dopo l'illustrazione della scorsa settimana ai consiglieri. Leggere il seguito
Il 05 dicembre 2013 da Digitalsat
NONE, NONE, NONE -
I’panino

.. lo street food per eccellenza! Gli dedico un post perchè dato il mio stile di vita attuale spesso mi fa compagnia. A pranzo un panino, a merenda un panino, a... Leggere il seguito
Il 05 dicembre 2013 da Melissa
NONE, NONE, NONE -
Shining, 26/11/2013

Bologna, Freakout. Sono stati mossi dei passi verso un miglioramento del Freakout, sede di una programmazione infinita e notevole, una valanga di gruppi che,... Leggere il seguito
Il 05 dicembre 2013 da The New Noise
NONE -
Sotto cieli noncuranti – Benedetta Cibrario

Durante la lettura di questo romanzo di Benedetta Cibrario – vincitrice del Premio Campiello 2007 con Rossovermiglio (che leggerò!) – uscito nel 2010, ho... Leggere il seguito
Il 05 dicembre 2013 da Linda Ferrando
NONE, NONE -
Prodotti terminati: Novembre 2013 (pochi ma buoni!)

Si si lo so sparisco e riappaio, sparisco e riappaio... questo periodo della mia vita è cosi e non ci posso fare proprio nulla... Leggere il seguito
Il 05 dicembre 2013 da Valez87
NONE -
Lierac ~ Soluzione micellare lenitiva riequilibrante

Prodotto: Soluzione micellare lenitiva e riequilibrante Produttore: Lierac Packaging: bottiglia scura in plastica contente 200ml di prodotto. Reperibilità: in... Leggere il seguito
Il 05 dicembre 2013 da Goldenvi0let
NONE, NONE -
Decorazioni di Natale faidate: Omino di Pandizenzero

Vabeh, ora che vi siete scaldati un pochino con le prime creazioni all’uncinetto uscite dalle sante mani della mammina, ..cominciamo a fare sul serio,... Leggere il seguito
Il 05 dicembre 2013 da Nonnaso
NONE, NONE, NONE, NONE -
7 Milioni di italiani saltano la colazione. Quali rischi per la salute?

Ben 7 milioni di italiani saltano regolarmente la colazione: il 14% della popolazione, mentre nel 2004 si toccava l'8%Ben 7 milioni di italiani saltano... Leggere il seguito
Il 05 dicembre 2013 da Informasalus
NONE -
Sony Pictures presenta il primo trailer italaino di The Amazing Spider-Man 2:...

Da pochi minuti abbiamo ammirato il primo trailer originale di The Amazing Spider-Man 2, ora però è tempo di ammirare la versione italiana appena rilasciat... Leggere il seguito
Il 05 dicembre 2013 da Frenckcinema
NONE -
Viva la mamma
Qualche settimana fa ho avuto un brutto scontro con mia madre. Per una cazzata, che lei ha ingigantito. In realtà, lo scontro tra me e mia madre avviene per... Leggere il seguito
Il 05 dicembre 2013 da Lanterna
NONE -
Stamina, il TAR annulla il Comitato scientifico e il suo parere. Tutto da rifare...
Il TAR del Lazio ha deciso il 3 dicembre l'annullamento, sospendendone l'efficacia,dei decreti del 18/06/2013 e del 28/08/2013 relativi al rilascio... Leggere il seguito
Il 05 dicembre 2013 da Paopasc
NONE -
La formula della vita - Il segreto della vitalità

"Finora non è ancora stato spiegato o dimostrato che cosa sia realmente la vitalità e quanto possa diventare sorprendente"«V» = «P» - «O» («V» è uguale a «P»... Leggere il seguito
Il 05 dicembre 2013 da Informasalus
NONE -
Il primo sfolgorante trailer di The Amazing Spider-Man 2

E' stato annunciato in grande stile nei giorni scorsi da Sony Pictures, ma ora è giunto il momento di lustrarsi gli occhi ed ammirare il primo sfolgorante... Leggere il seguito
Il 05 dicembre 2013 da Frenckcinema
NONE -
O gringo não conhece

Facciamo subito una premessa: a me, che gli stadi del Mondiale di Calcio vengano costruiti in tempo, non me ne importa niente. Leggere il seguito
Il 05 dicembre 2013 da Brasilitalia
NONE, NONE -
I fondali del Metodo Classico trentino
Il Conte – Qualcuno si muove e affonda lo spumante. Dove? Nel lago di Levico, in Valsugana, che, come Caldonazzo, Toblino e molti altri, vive vita tranquilla,... Leggere il seguito
Il 05 dicembre 2013 da Trentinowine
NONE, NONE -
“...Offelée fa el tò mestèe…" (di Axel) - Piccola a storia di miracoli e...

Affinità somatiche? Davide Vannoni Gianroberto Casaleggio Mettiamola così: davvero pensate che scegliersi un protocollo medico sia un diritto di ogni... Leggere il seguito
Il 05 dicembre 2013 da Tafanus
NONE -
Motorola Moto X sta già ricevendo Android 4.4 KitKat

Il primo smartphone non Nexus, e nemmeno Google Developer Edition, a ricevere l’aggiornamento Android 4.4 KitKat è il Motorola Moto X. Leggere il seguito
Il 05 dicembre 2013 da Fabio Franciosi
NONE -
Giovanni Battista Belzoni, archeologo e avventuriero, visto da Walter Venturi

Venturi e il suo BelzoniWalter Venturi approda, nella duplice veste di autore e disegnatore, nella prestigiosa collana dei “Romanzi a fumetti Bonelli”,... Leggere il seguito
Il 05 dicembre 2013 da Lospaziobianco.it
NONE, NONE, NONE -
Il settimanale l’Espresso contro chi tutela la maternità

Si riconferma la realtà che chi sostiene l’interruzione di gravidanza è contrario al diritto alla vita, alla salute materna e alla tutela della donna. Leggere il seguito
Il 05 dicembre 2013 da Uccronline
NONE, NONE -
Del Miracolo del Capello Autopulente e di altri demoni
Mi dicono che è trascorso quasi un mese dal mio ultimo post. Alcune di voi con la solita grazia e delicatezza mi hanno fatto sapere che la Polizia ha iniziato l... Leggere il seguito
Il 05 dicembre 2013 da Nenecherie
NONE -
Per i marò no per i teppisti si
Sicuramente è una semplice concomitanza temporale il fatto che il nostro Capo del Governo, Enrico Letta, sia in visita ufficiale in Polonia e,... Leggere il seguito
Il 05 dicembre 2013 da Ritacoltellese
NONE, NONE -
Fox, il 15% dei ricavi pubblicitari arriva dalle iniziative di brand content...

Il gruppo Fox International Channels Italy chiuderà un 2013 con raccolta pubblicitaria in crescita a una cifra sul 2012, e supererà quindi di slancio, in base... Leggere il seguito
Il 05 dicembre 2013 da Nicoladki
NONE, NONE -
prendiamoli a testate nazionali
A pranzo alla mensa di uno dei principali gruppi editoriali, ospite di un amico, mi appunto mentalmente due particolari che so che prima o poi utilizzerò da... Leggere il seguito
Il 05 dicembre 2013 da Plus1gmt
NONE -
Aiutiamo i nostri bambini ad essere creativi, è facile

Creativi non si nasce, ma si diventa. Aiutiamo i nostri bambini ad essere creativi, è facile. La creatività è un’abilità che si apprende, si può migliorare e... Leggere il seguito
Il 05 dicembre 2013 da Antonioriccipv
NONE, NONE -
Minority Report

La dichiaro in arresto per il futuro omicidio di… Titolo: Minority Report Regia: Steven Spielberg Cast: Tom Cruise, Colin Farrell, Samantha Morton, Max von Sydo... Leggere il seguito
Il 05 dicembre 2013 da Sbruuls
NONE, NONE -
Canis et porcellum ! ! !
Bocciato Porcellum,Padellaro:"Sentenza come una bomba,si delegittima tutto"Il video-editoriale del direttore de il Fatto Quotidiano sulla decisione della... Leggere il seguito
Il 05 dicembre 2013 da Pinoz6700
NONE, NONE -
Super Mario 3D World – Recensione

Wii U TESTATO SUWII U Genere: Piattaforma Sviluppatore: Nintendo Produttore: Nintendo Distributore: NintendoLingua: Italiano Giocatori: 5 Data di uscita:... Leggere il seguito
Il 05 dicembre 2013 da Videogiochi
NONE, NONE, NONE -
Battibecchi
Nel film La ragazza del lago Toni Servillo recita questa battuta: «Qualcuno mi deve spiegare perché le donne, quando litigano, litigano di spalle…». Ecco, me... Leggere il seguito
Il 05 dicembre 2013 da Iltondi
-
SED: Store for Emerging Designer

Scelgono i propri i designer tra le fiere e le numerose candidature pervenute sul loro sito. In un prodotto cercano creatività, particolarità e vendibilità; in... Leggere il seguito
Il 05 dicembre 2013 da Harimag
NONE -
Life is a... Book: Tu Cuerpo

Vacanze. Meritate, agognate e tanto aspettate vacanze e ancor di più quando alle spalle si aveva avuto un anno tanto duro e difficile come quello che avevano... Leggere il seguito
Il 05 dicembre 2013 da Cristina Petrini
-
Voglio fare la Letterina
<<Allora...vediamo.....un robot da cucina non sarebbe male....però,prima vorrei tanto la macchina per fare i cupcake che son tanto di moda....>>Che... Leggere il seguito
Il 05 dicembre 2013 da Doppiogeffer
NONE, NONE, NONE, NONE -
Arriva l’airbag per smartphone, ma prima dovete sapere che…

Scritto da: Luisa Cassarà 5 dicembre 2013 in Tecnologia Inserisci un commento 61 visite tweet Soluzione anti-caduta Il pericolo numero 1 di ogni smartphone... Leggere il seguito
Il 05 dicembre 2013 da Moveup
-
Assassini in alto mare - Recensione - iPhone

La serie di Assassin's Creed torna sui dispositivi mobile per raccontarci la storia del pirata Alonzo Batilla Considerando il fatto che giochi come The Amazing... Leggere il seguito
Il 05 dicembre 2013 da Intrattenimento
NONE, NONE -
Un disegno politico da Prima Repubblica anti-bipolarismo

Un estratto del libro di Marco Travaglio "Viva il re" (Chiarelettere), sul presidente della Repubblica Napolitano: questa una parte del capitolo (che trovate su... Leggere il seguito
Il 05 dicembre 2013 da Funicelli
NONE -
Torta al mascarpone

Oggi per me è un grande giorno!!!!!!!!13 anni fa precisamente alle 16.35 sono diventata mamma!!!!!Un 'emozione unica in cui cominciano una serie di sensazioni... Leggere il seguito
Il 05 dicembre 2013 da
NONE, NONE -
Il librottino di dicembre [più il resoconto di novembre]
![librottino dicembre [più resoconto novembre]](https://m21.paperblog.com/i/208/2089582/il-librottino-di-dicembre-piu-il-resoconto-di-L-GkwvR7-175x130.png)
Prima di mostrarvi il librottino di dicembre, vedo di fare un bilancio di questo novembre (qui, se volete, trovate il libricino dello scorso mese). Via al... Leggere il seguito
Il 05 dicembre 2013 da Frufru
NONE, NONE -
Playstation 4: prime impressioni

Tutto sommato ho fatto abbastanza presto a decidermi, nonostante fingessi di studiarci un po' su. Lo scontro diciamo che non vedeva un prodotto vincere... Leggere il seguito
Il 05 dicembre 2013 da Vomitoergorum
-
Dalla Terra dei Cachi alla Terra dei Fuochi, subito il Decreto

Arriva il Decreto Terra dei Fuochi. È il momento delle grandi scoperte. In questi giorni abbiamo scoperto molte cose, tra le quali: che il Porcellum è... Leggere il seguito
Il 05 dicembre 2013 da Ediltecnicoit
NONE -
La Repubblica degli illegittimi

Ci sono voluti otto lunghi anni perché finalmente il Porcellum finisse di grufolare e alla fine ci ha dovuto pensare la Corte Costituzionale, visto che il... Leggere il seguito
Il 05 dicembre 2013 da Albertocapece
NONE, NONE -
Un anno con Eat Piemonte

Eat Piemonte ha compiuto un anno. E per festeggiarlo Dario Ujetto, il suo creatore, ha pensato di fare le cose in grande. Ha infatti ideato, insieme al fotograf... Leggere il seguito
Il 05 dicembre 2013 da Sarahscaparone
NONE, NONE -
La non fine del porcellum

E' come se, dopo aver scoperto che l'inquilino cui hai affittato caso non ti ha pagato per anni e iu giudice stabilisce che l'inquilino se ne deve andare. Perch... Leggere il seguito
Il 05 dicembre 2013 da Funicelli
NONE -
Blue cinema

Condividi Sta per arrivare il Natale, evviva! Evviva cosa? Il Natale, come ben sappiamo, in Italia significa due cose: panettone e cinepanettone. Leggere il seguito
Il 05 dicembre 2013 da Cannibal Kid
NONE, NONE, NONE -
Thursday's child

La trama (con parole mie): ci avviamo alla conclusione dell'anno, alle classifiche che decreteranno il suo meglio ed il peggio, e prima che i Cinepanettoni... Leggere il seguito
Il 05 dicembre 2013 da Misterjamesford
NONE, NONE -
[Swatches] e [Review] Catrice LE Feather & Pearls e le mie opinioni sul sito...
![[Swatches] [Review] Catrice Feather Pearls opinioni sito Kosmetik Kosmo.](https://m22.paperblog.com/i/208/2089480/swatches-e-review-catrice-le-feather-pearls-e-L-oAow0s-175x130.jpeg)
Buongiornino bellezze! In questo post vi parlerò della mia esperienza con il sito tedesco Kosmetik Kosmo , di cui vi avevo parlato in un post precedente. Leggere il seguito
Il 05 dicembre 2013 da Nothingeasier
NONE -
Aleister Crowley, l’Hashish mistico della Bestia

Aleister Crowley (1875 – 1947) è una delle figure più emblematiche che si affermano a cavallo tra il XIX e il XX secolo. Dalla stampa Britannica fu considerato... Leggere il seguito
Il 05 dicembre 2013 da Wsf
NONE, NONE -
Italia allo sbando

Non sono un esperto di diritto Costituzionale ma, alla luce della sentenza della Corte Costituzionale che ha stabilito l'illegittimità del Porcellum, immagino... Leggere il seguito
Il 05 dicembre 2013 da Vincitorievinti
NONE, NONE, NONE -
Pebble Smartwatch: recensione e videorecensione di YourLifeUpdated
Il Pebble è senza dubbio un ottimo smartwatch. E’ compatto, leggero, piccolo e soprattutto non ingombra eccessivamente il nostro polso. Leggere il seguito
Il 05 dicembre 2013 da Riccardo Conti
NONE, NONE -
Content Marketing: la rivoluzione dei contenuti

La rivluzione dei contenuti: partendo dalla presentazione fatta da Alberto Mari di Outbrain, qui di seguito trovate spunti e riflessioni su questa frontiera... Leggere il seguito
Il 05 dicembre 2013 da B2corporate
NONE, NONE, NONE, NONE, NONE -
Rassegna giovedì 5 dicembre 2013

PILLOLE NAZIONALI GIOVEDì 5 DICEMBRE 2013 LA CONSULTA: PORCELLUM INCOSTITUZIONALE Via premi di maggioranza e liste bloccate. Leggere il seguito
Il 05 dicembre 2013 da Margheritapugliese
NONE, NONE -
Dai, poche storie, Domenica vai a votare!
Il Partito Democratico, per ovviare alle liste bloccate imposte dal Porcellum, circa un anno fa ha tenuto primarie aperte, unico partito in Italia eccetto SeL,... Leggere il seguito
Il 05 dicembre 2013 da Elianigris
NONE, NONE -
Recensione a Caldo – La mafia uccide solo d’estate

Grande senso del ritmo, attori quasi tutti efficacissimi, la cronaca e la commedia uniti in maniera uniforme e efficace come raramente accade nel cinema... Leggere il seguito
Il 05 dicembre 2013 da Fabioeandrea
NONE -
Perché voto alle Primarie del Partito Democratico: tre regolette d'oro per...

Lo Sky format che ha ospitato il confronto dei gladiatori più gladia che tori del PD è semplicemente AGGHIACCIANTE. Più di Berlusconi da Santoro. Leggere il seguito
Il 05 dicembre 2013 da Nicola_pedrazzi
NONE, NONE, NONE -
Danni da vaccino contro il Papilloma virus - alcune notizie dalla Francia e la...

A completamento della storia della ragazza che ha manifestato sintomi simili a quelli della sclerosi a placche dopo la vaccinazione contro il papilloma virus,... Leggere il seguito
Il 05 dicembre 2013 da Corradopenna
NONE -
Oggetti intelligenti

Presto avremo relazioni più ricche e utili con gli oggetti attorno a noi; grazie alla dotazione di tecnologie intelligenti (“smart”) potremo avere un... Leggere il seguito
Il 05 dicembre 2013 da Karlus71
NONE, NONE -
I bambini fanno “oh merda!”

foto: http://www.ilgiornale.it/news/sport/multa-juventus-offese-dei-bambini-stadio-973026.html... Leggere il seguito
Il 05 dicembre 2013 da Marvigar4
NONE -
Antonio Ferrara intervista Francesco Basso

Gordiano Lupi Francesco Basso Oggi per “Uno sguardo oltre la siepe” ho il piacere di intervistare lo scrittore e giornalista Francesco Basso da poco in... Leggere il seguito
Il 04 dicembre 2013 da Dobermann
NONE, NONE -
alcuni aneddoti dal futuro degli altri | 04.12.13
il Post, “Come si vota alle primarie del PD”: La guida definitiva sull’elezione del nuovo segretario del Partito Democratico, il prossimo 8 dicembre: chi deve... Leggere il seguito
Il 04 dicembre 2013 da Plus1gmt
NONE -
Quale partner può davvero essere irresistibile per noi? – Marte e Venere in LEONE

In molte rubriche astrologiche il Leone è spesso descritto come il segno che più di tutti gli altri è in grado di lasciare nel suo ambiente un’impronta di... Leggere il seguito
Il 04 dicembre 2013 da Astromanica
NONE, NONE -
TAG: Voi mi avete delusa!#1: i 3 prodotti che non ricomprerò!

Salve bellezze! Nuova rubrica oggi sempre in collaborazione con Beatrice del blog BeautyTude! Stavolta per parlarvi dei 3 prodotti che proprio non mi sono... Leggere il seguito
Il 04 dicembre 2013 da The Secret Garden Of Roses
NONE -
SPOILER su TVD 5, The Following 2, Modern Family 5, The Mentalist 6, Arrow 2,...

Ancora scoop circa un fantomatico triangolo amoroso a Mystic Falls. La nuova vita di Joe Carroll e la sua antipatia per Ryan Hardy. Un nuova battaglia... Leggere il seguito
Il 04 dicembre 2013 da Linda93
NONE, NONE -
RECENSIONE A FREDDISSIMO – Oh Boy, un caffè a Berlino

Tanti auguri a Jan Ole Gerster per il buon risultato di Oh Boy, un caffè a Berlino, pellicola in bianco e nero tedeschissima che ha avuto notevoli risonanze... Leggere il seguito
Il 04 dicembre 2013 da Fabioeandrea
NONE -
Uffici stampa, vi amo

Io sono innamorato di tutti gli uffici stampa che promuovono i libri per le case editrici, e questa è la mia dichiarazione d’amore. Leggere il seguito
Il 04 dicembre 2013 da Bernardrieux
NONE, NONE, NONE -
Corruption Perceptions Index 2013
È uscito l'annuale rapporto di Trasparency International, l'organizzazione non governativa che stila la classifica sulla trasparenza delle istituzioni... Leggere il seguito
Il 04 dicembre 2013 da Danemblog
NONE -
Il tar del lazio dice si al metodo stamina

Il Tar del Lazio ha sospeso il decreto di nomina della Commissione del Ministero della Salute che ha bocciato il 'metodo Stamina'. Di conseguenza è sospeso anch... Leggere il seguito
Il 04 dicembre 2013 da Antonella Di Pietro
NONE -
I tassi sotto zero congelano la deflazione

di Andrea Terzi (*) - ateconomics.com Rispondendo alle domande dell’ultima conferenza stampa, il presidente della Banca Centrale Europea Mario Draghi ha... Leggere il seguito
Il 04 dicembre 2013 da Keynesblog
NONE, NONE, NONE -
Recensione di "Il ritornante - La città inferiore" - Lorenzo Manara

Cari visitatori della Tana,vi parlo oggi di un romanzo che ho sul Kindle da tempo, ma che ho cominciato a leggere solo una decina di giorni fa. Si tratta di Il... Leggere il seguito
Il 04 dicembre 2013 da Annie_caffeine
NONE -
Recensione: L'ostinato silenzio delle stelle

Titolo: L'ostinato silenzio delel stelle Autore: Massimiliano Malerba Editore: Wild Boar Pagine: 126 Prezzo: 11,00 euro Descrizione: Dal 2011 l'associazione... Leggere il seguito
Il 04 dicembre 2013 da Flautodipan
NONE, NONE -
169. in attesa del torneo di arti marziali

from Tutto Dragonball on Vimeo.Goku e Gohan decidono di passare più della metà dei nove giorni rimanenti prima del torneo a riposare. Leggere il seguito
Il 04 dicembre 2013 da Emiliods88
NONE -
Dischi e discoboli - seconda parte

Seconda parte: la possessione diabolica.Ed eccoci nuovamente con una nuova sfilza di nano-recensioni scritte in fretta e male dal discobolo folle che si è... Leggere il seguito
Il 04 dicembre 2013 da Ant
NONE, NONE -
Dopo l’improvvisa morte di Paul Walker cosa ne sarà di Fast & Furious 7: Tra...

Dopo l’improvvisa morte di Paul Walker si è sollevato un importante quesito: cosa ne sarà della saga di Fast Furious? Potrebbe sembrare indelicato parlare... Leggere il seguito
Il 04 dicembre 2013 da Nicoladki
NONE, NONE -
Babywearing

Quando è nata la mia prima figlia tra le cose che mi hanno prestato c’era un bel marsupio.Complice il fatto che lei era magrina e che prendere peso in tempi... Leggere il seguito
Il 04 dicembre 2013 da Bimbiuniverselaura
NONE, NONE, NONE -
L’Ucraina attende ancora la sua rivoluzione
Il significato originale di Ucraina è “confinante, di frontiera”. La sua posizione in bilico tra l’est e l’ovest l’hanno infatti resa a un tempo culla e... Leggere il seguito
Il 04 dicembre 2013 da Luca Troiano
NONE, NONE, NONE -
Il sorpasso

Il recente sorpasso dello yuan sull’euro per quanto concerne le transazioni finanziarie internazionali rappresenta il coronamento della strategia di ampio... Leggere il seguito
Il 04 dicembre 2013 da Eurasia
NONE, NONE, NONE -
Le comiche di Stanlio e Olli

La campagna elettorale europea è cominciata: Ollie Rehn il finlandese cooptato nel 2009 dai burocrati europei senza che nessuno mai lo abbia eletto, né in patri... Leggere il seguito
Il 04 dicembre 2013 da Albertocapece
NONE, NONE -
Kinshasa e l’energia carismatica del sorriso

Africa. Sei lettere. Ma mai una parola è stata così imponente per me. Mai come in questi giorni. L’Africa è un continente immenso di cui si parla da sempre, ma ... Leggere il seguito
Il 04 dicembre 2013 da Sarahscaparone
NONE -
Dialogo di civiltà in Kazakhstan: intervista a Mons. Athanasius Schneider
In occasione dell’imminente uscita del libro L’unità nella diversità. Religioni, etnie e civiltà del Kazakhstan contemporaneo (a cura di Dario Citati e... Leggere il seguito
Il 04 dicembre 2013 da Geopoliticarivista
NONE, NONE, NONE -
Il regno dei lupi di George R.R. Martin. Capitolo 3: Tyrion

La copertina dell’edizione slovena di A Clash of Kings Il primo capitolo di Tyrion nel Regno dei lupi è uno di quei sempre più rari casi in cui un capitolo... Leggere il seguito
Il 04 dicembre 2013 da Martinaframmartino
NONE, NONE -
Intake – Recensione

PC TESTATO SUPC Genere: Arcade, Sparatutto Sviluppatore: Cipher Prime Studios Produttore: Cipher Prime Studios Distributore: Digital DeliveryLingua: Inglese... Leggere il seguito
Il 04 dicembre 2013 da Videogiochi
NONE, NONE, NONE -
Essence I ♥ Extreme mascara

Essence I Love Extreme, nome perfetto per la gioia di noi menti deviate che vediamo cose zozze in ogni dove!In ogni caso... Era un po' che facevo il filo a... Leggere il seguito
Il 04 dicembre 2013 da Leesose
NONE, NONE -
GLI OCCHI DELLE FALENE – Il futuro del solare nei loro occhi

ABBIAMO PIU’ VOLTE SPIEGATO COME IL FOTOVOLTAICO SIA IN CONTINUA EVOLUZIONE. Non si fa in tempo ad assimilare una nuova soluzione, che subito qualcun altro... Leggere il seguito
Il 04 dicembre 2013 da Ilfattaccio
NONE, NONE